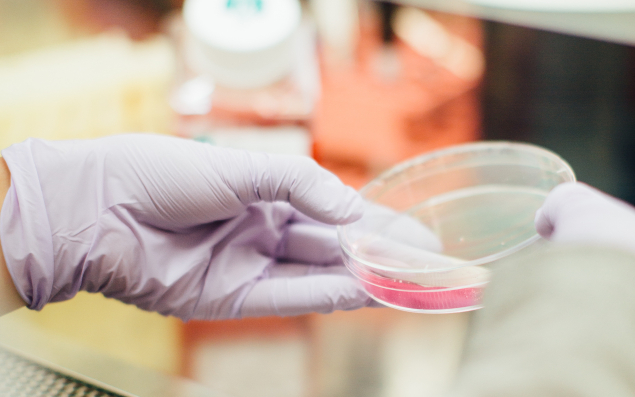

Le projet collaboratif Blue Train, qui vise à former l'ensemble des acteurs de l'économie maritime bretonne aux évolutions du secteur des biotechnologies marines, atteint un montant global de 13,8 millions d'euros. Blue Train, qui devrait former près de 300 personnes par an pendant cinq ans, est porté par la station biologique de Roscoff, aidée par 18 entreprises locales, des universités et des organismes de formation. Ce projet s’inscrit dans le projet de parc scientifique Blue Valley.